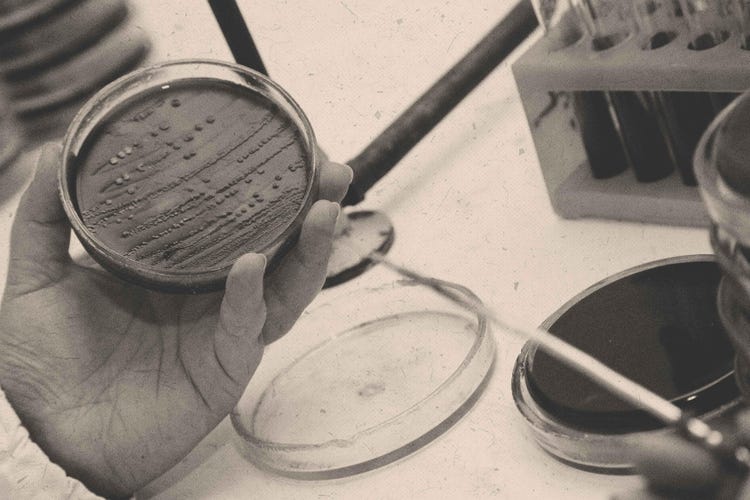

DE QUE FORMA FUNCIONAM OS ANTIBIÓTICOS.
Os antibióticos podem, por exemplo, matar bactérias ou inibir a sua multiplicação.
UMA INVENÇÃO QUE MUDOU A MEDICINA.
Antibióticos são medicamentos formados por microorganismos, como bactérias ou certos tipos de fungos. Na luta pelo seu habitat, eles usam antibióticos como arma para matar outros microorganismos. O pesquisador escocês Alexander Fleming descobriu essa propriedade no final da década de 1920 e tornou-a utilizável para seres humanos. Nas suas experiências, descobriu que os antibióticos também podem matar bactérias patogénicas no corpo humano. Denominou a sua descoberta de penicilina, o primeiro antibiótico a tratar com sucesso uma pessoa com uma infeção bacteriana.
OS DIFERENTES MODOS DE AÇÃO DOS ANTIBIÓTICOS.
O efeito bactericida mata bactérias.
O efeito bacteriostático inibe a multiplicação de bactérias tão fortemente que o nosso sistema imunológico pode combater as bactérias patogénicas de forma independente.
É feita uma distinção básica entre antibióticos de espetro estreito, que são eficazes apenas contra algumas bactérias, e antibióticos de largo espetro, que atuam contra diferentes bactérias patogénicas.
Os antibióticos são inofensivos aos seres humanos porque não danificam as células humanas. No entanto, vários efeitos secundários podem surgir. Antibióticos causam frequentemente queixas gastrointestinais, erupções cutâneas ou reações alérgicas. Muitos pacientes queixam-se de diarreia. Isso ocorre porque as preparações com antibióticos não matam apenas as bactérias causadoras de doenças, quando ingeridas, mas também combatem as bactérias intestinais benéficas que ajudam a digestão na flora intestinal e são importantes para o sistema imunológico. Tomar probióticos antes e durante o tratamento com antibióticos pode ajudar a reconstruir a flora intestinal.
Se ocorrerem efeitos secundários durante o tratamento, é sempre aconselhável consultar um médico ou farmacêutico. Para evitar interações medicamentosas, deverá informar o seu médico ou farmacêutico sobre os medicamentos que, atualmente, está a tomar.

O folheto informativo fornece informações sobre riscos e efeitos colaterais.



